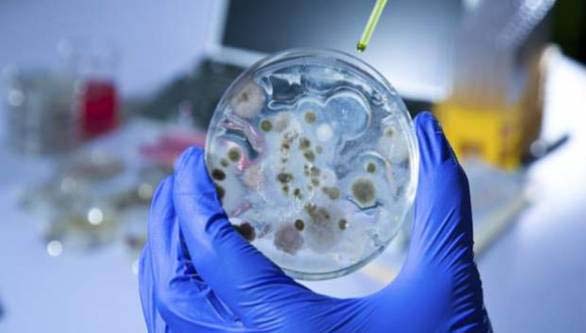

На подручју Сокоца потврђен је антракс код двије угинуле овце.
Шта је заправо антракс и колико је опасан за животиње и људе, разговарали смо са помоћником министра пољопривреде Негославом Лукићем.
"Овдје се ради о једном бактеријском обољењу које изазива бактерија бацилус антрацис. Зооноза је, што значи да оболијевају и људи. Зато је важно рећи да, уколико фармери уоче да је упгинула животиња, одмах се јави у надлежну ветеринарску организацију како би се тај леш што прије уклонио са површине", рекао је Лукић за АТВ.
Када је ријеч о обољењима код људи, објаснио је да се симптоми обично јављају на кожи.
Упозорио је и да уколико се зараза унесе удисајима, обољење може бити смртоносно.
Више детаља о овој опасној болести погледајте у видео прилогу.